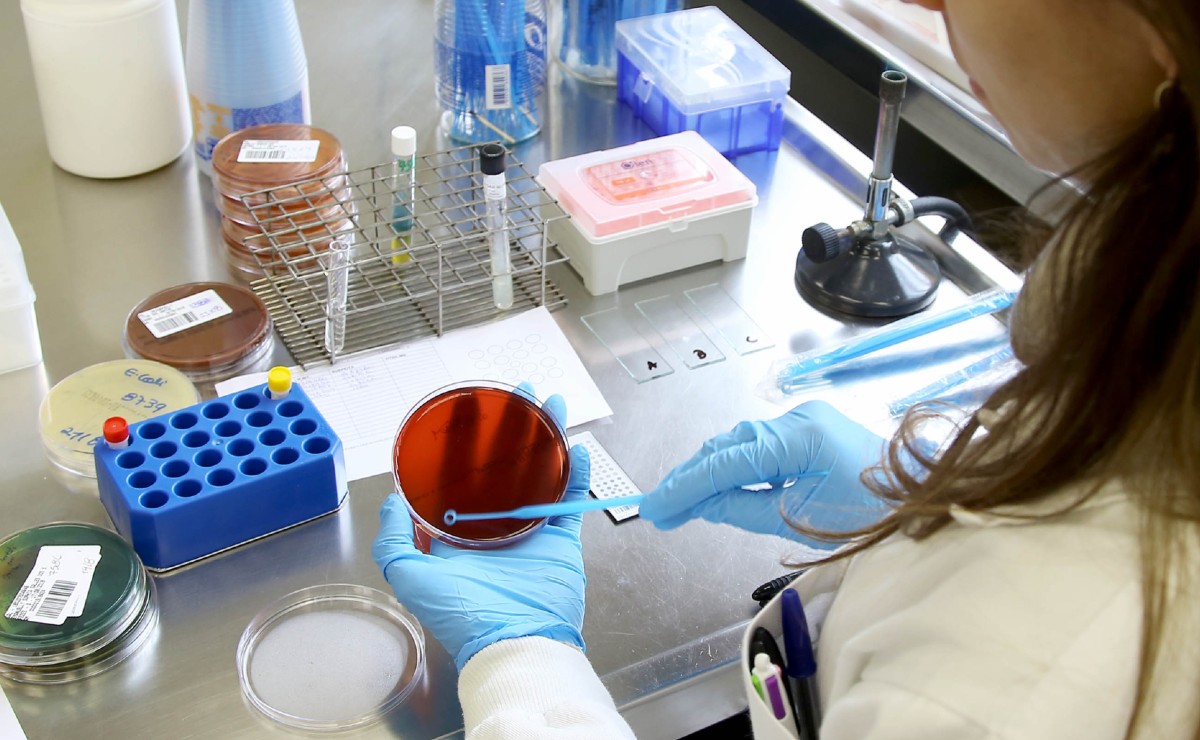

Até o final de abril, mais 17 agentes vão reforçar o quadro do Laboratório Central do Estado (Lacen-PR), responsável pelos exames de contraprova para a covid-19. A doença, até o boletim desta segunda-feira, tinha três mortes e 160 casos confirmados no Paraná. Segundo o Lacen, a equipe da Divisão dos Laboratórios de Epidemiológica e Controle de Doenças (DVLED) passará de 60 para 77 agentes até o fim de abril. Outros 74 já foram incorporados ao dia a dia. O Lacen analisa, atualmente, 600 amostras por dia.
+Viu essa? Álcool contra coronavírus liga alerta pra queimaduras: como usar corretamente
De todos os 17 novos agentes em operação no Lacen em São José dos Pinhais, região metropolitana de Curitiba, cinco foram deslocados do Lacen-PR de Curitiba. Outros nove são bolsistas, de nível técnico e superior, ligados à Universidade Federal do Paraná (UFPR). Estes já começaram os trabalhos nesta segunda-feira (30).
Além destes, mais três pessoas vão integrar o quadro ainda em abril. O lacen ressalta que as contratações são temporárias, duas delas via inexigibilidade de licitação devido à pandemia, o que viabiliza o pagamento por meio de Recibo de Pagamento Autônomo (RPA).
“O Lacen fez um grande esforço de trabalho nas últimas semanas e está operando à plena capacidade para dar respostas cada vez mais ágeis. O laboratório tem papel fundamental na estratégia de contenção da Covid-19”, disse o secretário de saúde da Saúde, Beto Preto.
Como prevenir a contaminação por coronavírus
- Lavar as mãos com frequência/ ou utilizar álcool 70%, principalmente antes de consumir algum alimento;
- Utilizar lenço descartável para higiene nasal;
- Cobrir nariz e boca quando espirrar ou tossir;
- Evitar tocar mucosas de olhos, nariz e boca, higienizar as mãos após tossir ou espirrar;
- Não compartilhar objetos de uso pessoal, como talheres, pratos, copos ou garrafas;
- Manter ambientes bem ventilados, evitar contato próximo com pessoas que apresentem sinais ou sintomas da doença;
- Evitar contato próximo com animais selvagens e animais doentes em fazendas ou criações;
- Pessoas com sintomas de infecção respiratória aguda devem praticar etiqueta respiratória (cobrir a boca e nariz ao tossir e espirrar, preferencialmente com lenços descartáveis, e depois lavar as mãos).